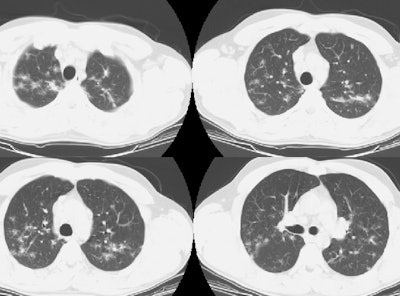
Ct Lung Small

Testicular Sarcoid:
Testicular Sarcoid:
The patient below presented with complaints of testalgia (most likely related to an episode of epididymitis). The testicular sonogram below includes images of the right (top) and left (bottom) testciles. There were two well circumscribed, relatively hypovascular, hypoechoic, approximately one centimeter masses identified- one in the right testicle, the other in the left. A chest radiograph was obtained as part of the patients diagnostic evaluation for presumed testicular carcinoma.

The chest radiograph demonstrated the presence of ill-defined masses predominantly within the upper zones of both the left and right lungs (Click here for coned view). There was associated soft tissue fullness in the azygous node region and the aorto-pulmonary window which suggested the presence of adenopathy. The hila appeared normal.

The soft tissue windows on CT scan revealed the presence of mediastinal adenopathy, but no definite hilar adenopathy. Lung windows are below.

The lung windows revealed the presence of ill-defined nodular densities predominantly in the upper lobes. The patient was presumed to have metastatic testicular carcinoma, but on biopsy, the patient was discovered to have sarcoid. Following treatment with a course of steroids, the testicular masses resolved.